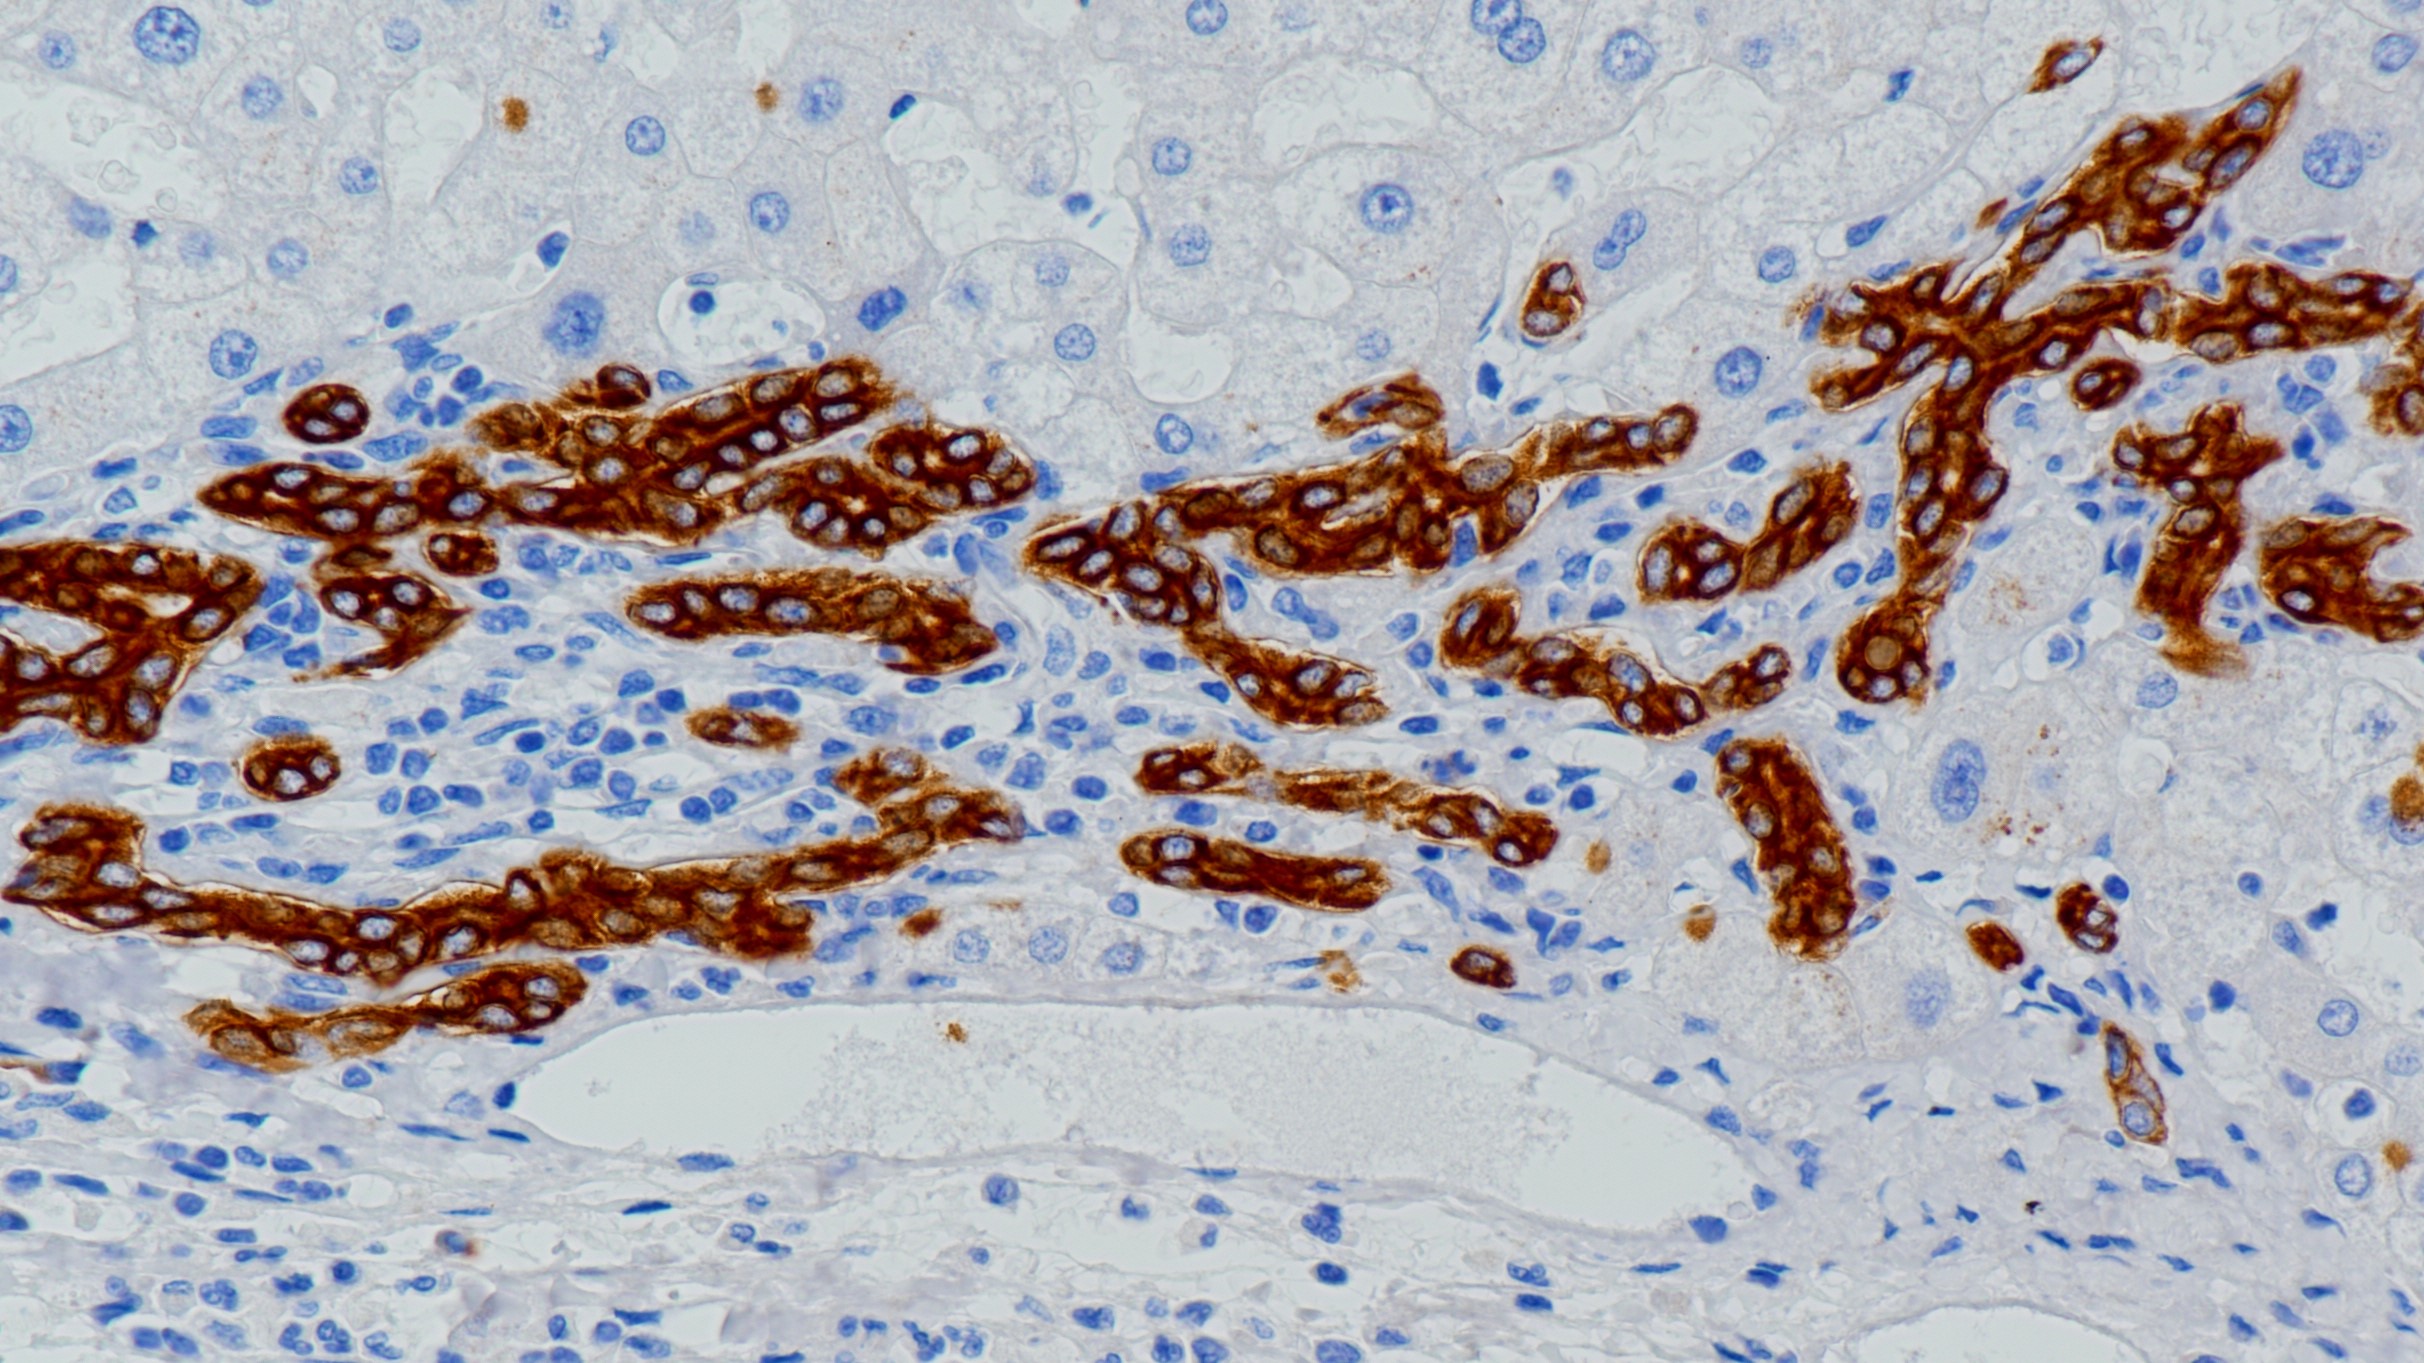
肝CK19(BP6022)染色

产品中心

结肠癌CK19(BP6022)染色
肝CK19(BP6022)染色
Cytokeratin 19(CK19) 重组兔单克隆抗体
细胞角蛋白19(CK19)是最小的角蛋白且非常罕见,因为它广泛缺乏所有其他角蛋白典型的非螺旋尾状结构域。它可能是由角质形成细胞角蛋白发展而来的。CK19在大多数简单上皮细胞中表达(不包括实质细胞如肝细胞,胰腺腺泡细胞和肾近端肾小管细胞),特别是在各种导管上皮细胞,小肠和大肠上皮细胞,胃小凹上皮细胞和间皮细胞中。此外,它存在于大多数假复层上皮细胞和尿路上皮细胞以及非角化复层鳞状上皮的基细胞中。在肿瘤中,CK19广泛表达于腺癌和鳞状细胞癌中,因此并不常用作癌分型的免疫组织化学标记物。CK19在大多数肝细胞中不表达,因此可用于鉴定肝转移,以及肝细胞特异性抗原的检测。
Specifications
- 产品注册名称
- 细胞角蛋白19抗体试剂(免疫组织化学)
- 目录号
- I1006
- 克隆号
- BP6022
- 亚细胞定位
- 细胞质
- 阳性对照
- 甲状腺癌
- 修复方式
- HIER
- 组织类型
- FFPE
- 规格
- 工作液:1.5mL/7mL
浓缩液:0.1mL/1mL
- 用途
- NMPA IVD
CE
Applicable platform
- Biolynx平台
- Leica平台
- Roche平台
- Dako平台
Reference
1.Barroeta JE et al. Endocr Pathol. 2006 Fall;17(3):225-34.
2.Schmitt AM et al. Am J Surg Pathol. 2007 Nov;31(11):1677-82.
3.中华医学会.《临床技术操作规范·病理学分册》.人民军医出版社,2004.


